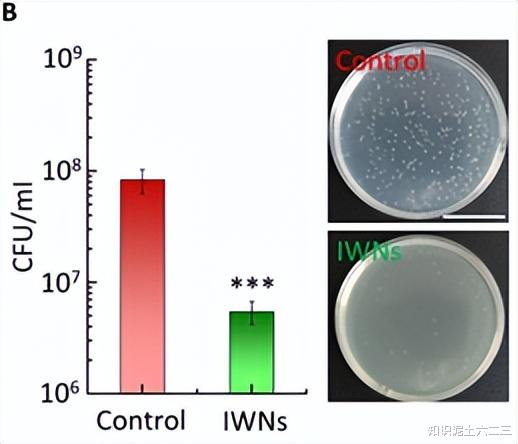

你是否注意过,蜻蜓在雨中飞行后翅膀依然干燥洁净,透明的翅膀几乎能 “隐身” 在空气中?这背后藏着大自然亿万年进化出的精密设计 —— 翅膀表面布满的纳米级凸起,兼具疏水、抗菌、抗反射等多重神奇功能。

*本文只做阅读笔记分享*
一、自然的神作:昆虫翅膀的 “纳米超能力”
自然界的昆虫早已进化出 “多功能纳米外衣”。研究发现,蜻蜓、透翅蝶、草蛉等多种昆虫的翅膀表面,都分布着周期约 100nm、高度 200-400nm 的不规则纳米柱。这些看似微小的结构,却是昆虫的生存法宝:
全方位抗反射:减少光线反射,让翅膀近乎透明,降低被天敌发现的概率;
物理抗菌:尖锐的纳米柱能刺破细菌细胞膜,实现无化学添加剂的杀菌效果;
疏水自清洁:让水滴无法附着,保持翅膀干燥以维持飞行能力。
这些纳米结构的高长径比、随机分布等特性,让传统纳米制造技术难以规模化复刻,长期以来限制了其在工业和民生领域的应用。

二、技术突破:激光 + 剥离,两步复刻自然奇迹
研究团队提出了一种极简的 “界面激光剥离”(lase-and-peel)策略,成功在超薄聚酰亚胺(PI)薄膜上批量制造出仿生昆虫翅膀纳米结构(IWNs),核心过程仅两步:
第一步:激光诱导,界面 “种” 出纳米柱
用紫外激光照射 PI - 玻璃界面,仅使靠近玻璃的 300nm 厚 PI 层熔化分解,产生的气体在界面处聚集,形成高密度纳米气泡。随着气泡不断生长、融合,逐渐在界面处塑造出纳米柱雏形。
第二步:机械剥离,同步成型双表面
通过热释放胶带(TRT)对 PI 薄膜施加剥离力,纳米柱在中间断裂,最终在 PI 薄膜和玻璃表面同时形成与天然昆虫翅膀高度相似的纳米结构。
这项技术的精妙之处在于,巧妙利用了传统激光剥离中的 “不完全界面分离” 现象,通过气泡融合与机械断裂的协同作用,快速形成不规则纳米柱。整个过程无需洁净室、真空环境,也无需化学试剂和掩膜,普通实验平台几分钟内就能完成制备,且可轻松扩展到手掌大小的大面积薄膜。

更令人惊喜的是,通过调节激光能量、照射次数和扫描策略,可精准控制纳米柱的直径、高度和分布。其形态与天然蜻蜓翅膀纳米结构的匹配度高达 90%,甚至复刻了天然结构的随机高度分布、顶部聚集和根部交联等细节特征。

三、超越自然:多功能薄膜的硬核实力
这种厚度不足 500nm 的仿生薄膜,不仅完美继承了天然昆虫翅膀的多功能特性,还在稳定性上实现了超越:
1. 光学性能拉满
在可见光范围内,仿生 PI 薄膜的透光率比普通薄膜提升约 7%,玻璃表面覆盖后透光率提升 3.7%。更厉害的是其全方位抗反射能力,即使大角度入射,性能依然稳定, haze 值低于 1%,清晰度极高。

2. 物理抗菌无残留
针对细胞壁厚、更难杀灭的革兰氏阳性菌(如金黄色葡萄球菌),仿生薄膜的杀菌率超过 95%。这种物理杀菌方式无需添加化学抗菌剂,避免了细菌耐药性和化学残留问题。
3. 疏水自清洁 + 超强稳定性
仿生薄膜的水接触角从普通 PI 薄膜的 85° 提升至 133°,可快速排斥小水滴。同时,它能承受手指按压、擦拭、水流冲击等机械作用,耐受 250℃高温和有机溶剂侵蚀,而天然昆虫翅膀在高温或有机溶剂中会迅速失去功能。

四、应用落地:从隐形眼镜到折叠屏,无处不在的黑科技
这些特性让仿生薄膜的应用场景无限拓展,研究团队已实现多个关键场景的技术验证:
多功能隐形眼镜:防眩光 + 抗菌 + 防 UV
将仿生薄膜通过水转移印刷技术集成到隐形眼镜表面,开发出兼具三重优势的新型隐形眼镜:

防眩光:有效消除环境光干扰,让眼动追踪在强光下依然精准,解决了虚拟现实(VR)/ 混合现实(MR)设备的核心痛点;

抗菌防感染:对眼部常见致病菌的杀菌率超过 96%,大幅降低长期佩戴隐形眼镜的感染风险;

紫外线防护:利用 PI 材料的固有特性,可完全阻挡紫外线,同时保持可见光高透光率。
在眼动追踪测试中,佩戴改性隐形眼镜的受试者能在强光干扰下,精准用眼球画出 “∞” 符号,而佩戴普通隐形眼镜则出现明显偏差。

柔性电子与光学器件
这种超薄柔性薄膜能无缝贴合到平面、曲面甚至皱纹表面(弯曲半径小于 500nm)。作为折叠屏的抗反射涂层,可减少折痕处的反光;作为骨科植入物的表面涂层,能实现物理抗菌并监测应力变化;还可用于光伏面板、光学镜头等,提升透光率和耐用性。
五、未来展望:从仿生到创新,解锁更多可能
这项技术为仿生纳米结构的规模化制造提供了全新思路,未来有望进一步拓展:
材料拓展:将制造体系扩展到更多高性能聚合物和透明基底;
结构优化:通过激光波长、偏振方向的调节,实现纳米 - 微米多级结构的精准构建;
功能集成:结合双面功能化和无损转移技术,开发兼具表面改性与实时传感功能的智能薄膜,甚至为 “仿生昆虫” 提供集成传感、通信功能的人工翅膀。
参考文献:
Jing Bian et al. Scalable manufacturing of multifunctional insect wing membrane via interfacial lase-and-peel strategy. Sci. Adv.11, eaea6934(2025).